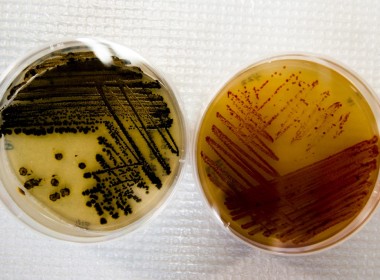

TOKYO, Japan (AFP) — Japan’s next-generation H3 rocket failed after liftoff on Tuesday, with the space agency issuing a destruct command after concluding the mission could not succeed. The failure is a blow for Japan’s space agency JAXA, after the rocket failed to even lift off on its first try last month. Tuesday’s launch from the Tanegashima Space Center in southwestern Japan initially appeared to be a success, with the flagship rocket lifting off at […]
Life
Smiley, dimpled sphinx statue unearthed in Egypt
Cairo, Egypt (AFP) — Archaeologists in Egypt have unearthed a sphinx statue “with a smiley face and two dimples” near the Hathor Temple, one of the country’s best preserved ancient sites, the tourism and antiquities ministry announced Monday. It is the latest in a series of discoveries revealed over the past few months. The limestone artefact, believed to be a stylised representation of an ancient Roman emperor, was found inside a two-level tomb near the […]
‘Rest your best!’: Pokemon Sleep game coming this year
Tokyo, Japan (AFP) — Pokemon’s last major smartphone hit, “Pokemon Go”, had fans on the move hunting the lovable characters, but its next release will focus on a more relaxing activity: sleep. The Pokemon Company has revealed it will release “Pokemon Sleep” across most of the world in summer 2023, four years after it first announced plans for the game. “Turn your sleep into entertainment,” the company said in a press release late Monday. Trailers […]
Goodbyes and good buys: Paris Fashion Week highlights
by Eric RANDOLPH Agence France-Presse PARIS, France (AFP) — The womenswear autumn-winter season finally comes to a halt on Tuesday, having rumbled through New York, London and Milan before ending in the French capital. Here are some of the highlights from the final set of shows in Paris. – Vivienne and Paco, au revoir – The fashion crowd said adieu to two titans of 20th century design. Vivienne Westwood’s widower Andreas Kronthaler presented something of […]
Satellites could beam poorest nations out of digital desert
by Tim Witcher Agence France-Presse Doha, Qatar (AFP) — Only a third of people in the world’s poorest countries can connect to the internet, the UN telecoms agency said Sunday, but low-flying satellites could bring hope to millions, especially in remote corners of Africa. Tech giants including Microsoft have pledged to help populations hobbled by poor internet services to “leapfrog” into an era of online connectivity, with satellites set to play a key role as […]
Machine magic or art menace? Japan’s first AI manga
by Tomohiro OSAKI Agence France Presse Tokyo, Japan (AFP) — The author of a sci-fi manga about to hit shelves in Japan admits he has “absolutely zero” drawing talent, so turned to artificial intelligence to create the dystopian saga. All the futuristic contraptions and creatures in “Cyberpunk: Peach John” were intricately rendered by Midjourney, a viral AI tool that has sent the art world into a spin, along with others such as Stable Diffusion and […]
Ten deadliest quakes of the past 100 years
Paris, France (AFP) — With a death toll standing at more than 50,000, the massive earthquake that struck Turkey and Syria on February 6 and its numerous aftershocks are among the 10 deadliest of the past century. – 1976: 242,000 dead, China – A quake measuring 7.8, according to the Chinese authorities, (7.5 according to the US Geological Survey), strikes near the industrial city of Tangshan in northeastern Hebei province. The official death toll is […]
‘Change’ for Iran women: Pastry chef rises to the occasion
Tehran, Iran (AFP) — She could have left Iran, as many of her contemporaries did, but Paris-trained pastry chef Shahrzad Shokouhivand decided to stay and work to make women’s lives better inside the country. And the icing on the cake? She and her husband now employ 70 people — mostly women. “It’s only by working here that we’ll change things in Iran,” said the 36-year-old, speaking to AFP in one of her two chic cafe-pastry […]
ChatGPT turns to manga in ‘One Piece’ author experiment
Tokyo, Japan (AFP) — The AI programme ChatGPT has passed exams, penned news articles and produced code. So perhaps no surprise that “One Piece” author Eiichiro Oda has turned to it for inspiration. The man behind the record-breaking manga often referred to as one of the best-known in the world seemed to have found himself struggling with writer’s block last month. “Hello. This is the author. I cannot come up with a story for One […]
SpaceX Dragon crew enter International Space Station
Washington, United States (AFP) — The SpaceX Dragon Endeavour spacecraft arrived at the orbiting station at 0640 GMT on Friday, the US space agency said in a statement. NASA’s Stephen Bowen and Warren Hoburg, Russia’s Andrey Fedyaev and Sultan al-Neyadi of the United Arab Emirates entered the station about two hours later, the livestream showed. A SpaceX Falcon 9 rocket carrying the spacecraft had blasted off to the station on Thursday after the launch was […]
Time US adults spend on TikTok closes in on Netflix: market tracker
San Francisco, United States (AFP) — TikTok is closing in on streaming giant Netflix when it comes to the amount of time US adults spend on the platforms, according to a report released Thursday by Insider Intelligence. TikTok use eclipsed that of YouTube two years ago and has continued to grow faster than the Google-owned video sharing platform, particularly among US adults in their prime earning years, the report indicated. “The amount of time US […]
Drugs from the deep: scientists explore ocean frontiers
by Kelly MACNAMARA Agence France-Presse PARIS, France (AFP) — Some send divers in speed boats, others dispatch submersible robots to search the seafloor, and one team deploys a “mud missile” — all tools used by scientists to scour the world’s oceans for the next potent cancer treatment or antibiotic. A medicinal molecule could be found in microbes scooped up in sediment, be produced by porous sponges or sea squirts — barrel-bodied creatures that cling to […]